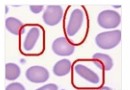

寶寶感冒咳嗽流鼻涕怎麼辦 熱水袋敷背與幫寶寶擠鼻涕
寶寶感冒咳嗽流鼻涕怎麼辦,小孩子的身體本來就比大人的要脆弱很多,所以寶寶就特別的容易感冒,那麼你知道寶寶感冒後流鼻涕應該怎麼辦嗎?熱水袋敷背與幫寶寶擠鼻涕。
(1)熱水袋敷背止咳法
熱水袋中灌滿40℃左右的熱水,外面用薄毛巾包好,然後敷於寶寶背部靠近肺的位置,這樣可以加速驅寒,對傷風感冒早期出現的咳嗽症狀尤為靈驗。
(2)滴母乳
母乳的溫熱度,可以讓寶寶的鼻腔暫時通暢。
(3)滴收縮鼻腔黏膜的藥
除了熱敷和母乳,還可以使用一些收縮鼻腔黏膜的兒童用藥,讓鼻粘膜血管收縮,減輕鼻塞。使用該類藥品時要注意,不要同時給兩個鼻孔滴藥,選擇鼻塞較重的一側滴入。每隔五分鐘到另一側鼻孔滴一次,一次一滴就可以了。
如果鼻腔內的分泌物引起堵塞,可以選用棉簽將物質黏出。或者刺激寶寶打噴嚏,讓將內裡的硬物直接排出。
(4)幫寶寶擠鼻涕
讓寶寶順暢呼吸的最有效的辦法。
(5)媽媽吃溫熱食物
還在吃母乳,母親要注意多吃溫熱的食物,幫助寶寶保持抗寒體質。
(6)紅糖水或者蒜瓣水
同時還可以喂孩子紅糖水或者蒜瓣水(2到3瓣大蒜煮開15分鐘,大孩子蒜瓣增加一倍)。
(7)溫水泡腳
如果寶寶只是寒氣侵體,則可以每天給孩子用溫水泡腳,直到微微出汗,然後飽飽的睡覺。
(8)墊高頭部
稍微緩解鼻塞的症狀。
如果寶寶鼻子堵了,爸媽可以在孩子的褥子底下墊上一、兩個毛巾,頭部稍稍抬高能緩解鼻塞,但千萬不要讓2歲以下的寶寶直接睡在枕頭上或將枕頭墊在床墊下,這樣很容易引起窒息或損傷脊椎。
(9)多喝溫水溫飲料
多喝溫熱的飲料可使寶寶黏痰變得稀薄,緩解呼吸道黏膜的緊張狀態,促進痰液咳出。最好讓寶寶喝溫開水或溫的牛奶、米湯等,也可以適量的喝點溫果汁。選刺激性較小的蘋果汁和梨汁等,不宜喝橙汁、西柚汁等柑橘類的果汁。
(10)水蒸汽止咳法
寶寶咳嗽嚴重,可讓寶寶吸入蒸汽;或者抱著寶寶在充滿蒸汽的浴室裡坐5分鐘,潮濕的空氣有助於幫助寶寶清除肺部的黏液,平息咳嗽。
以上就是 小編為你講述的寶寶感冒咳嗽流鼻涕怎麼辦,寶寶的抵抗力是比較差的,所以寶寶感冒後父母應該多關注孩子的情況,可以讓寶寶多喝溫水溫飲料,並且墊高寶寶的頭部。
- 寶寶健康
-
寶寶肥胖會帶來哪些傷害
人們常覺得瘦弱的孩子營養不良,看著可憐;胖乎乎的孩
-
如果手足口病好了還會復發嗎
概 述 我們大家都知道,手足口病是一種在
-
0
寶寶在0~3歲間需要進行8次體檢,寶寶的定期體檢應該像規
-
專家談寶寶發育正常標准
概 述 每一個小寶貝都是父母的手心肉,孩